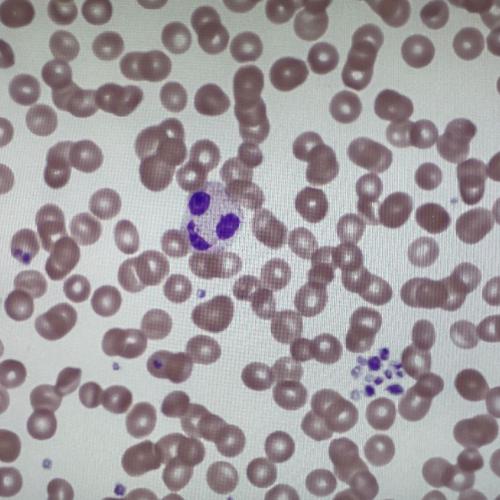
Blut
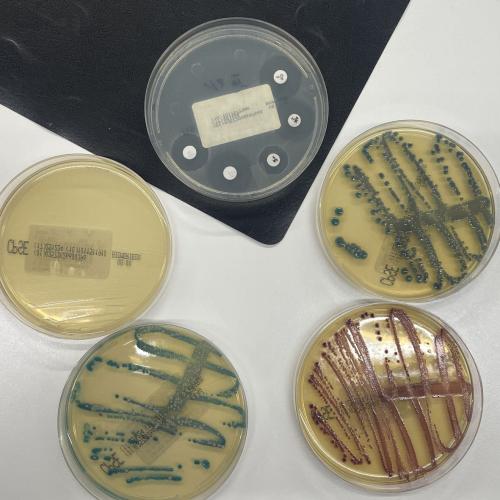
Bakterien

Ein Blick hinter die Kulissen - Das Labor des BKH Lienz
Die Schüler:innen der 1. und 2. Klasse des Aufbaulehrganges besuchten vergangene Woche im Rahmen des Unterrichtsfaches Mensch–Gesundheit–Soziales das Labor des Bezirkskrankenhauses Lienz.
Frau Margit Mattersberger, BSc (Biomedizinische Analytikerin), gestaltete eine äußerst interessante Führung für uns. Wir durften alle Bereiche des Labors besichtigen und erhielten spannende Einblicke in den abwechslungsreichen Arbeitsalltag des Laborpersonals.
Welches Probenmaterial wird im Labor untersucht? Welche Blutparameter werden analysiert? Wie und zu welchem Zweck wird eine Blutgruppe bestimmt? Wie sehen Blutzellen unter dem Mikroskop aus? Wie testet man die Wirksamkeit von Antibiotika? Und wie sehen Bakterien auf einer Agarplatte aus? All dies und vieles mehr wurde uns anschaulich erklärt.
Wir danken dem Bezirkskrankenhaus Lienz und dem gesamten Laborteam herzlich für diesen lehrreichen Ausflug.